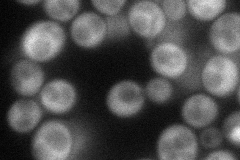
YDR169C
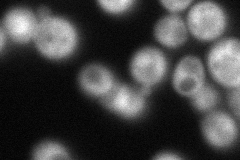
YDR169C
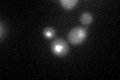
YDR169C
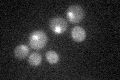
YDR169C

View description
Ribosomal RNA processing element (RRPE)-binding protein involved in the induction of non-ribosomal protein growth genes by glucose; binds Sin3p in a two-hybrid assay
Localization:
Intensity:
Fold change:
Significance:
-
C’ GFP library in SD

cytosol27.74 -
N' NOP1pr-GFP in SD
cytosol,nucleus68.558 -
N' TEF2pr-mCherry in SD
ER,vacuole72.3444 -
N' NATIVEpr-GFP in SD

cytosol24.3986 -
N' TEF2pr-VC and Cyto-VN in SD

#N/A0 -
C’ GFP library in SD+DTT
nucleus38.351.38Yes -
C’ GFP library in SD+H2O2

nucleusN/AN/ANo -
C’ GFP library in Starvation Media
nucleusN/AN/AYes -
C’ GFP library on the background of Pup2-DaMP

cytosol -
C’ GFP library on the background of CCT mutant

cytosol32.54191.17277No
